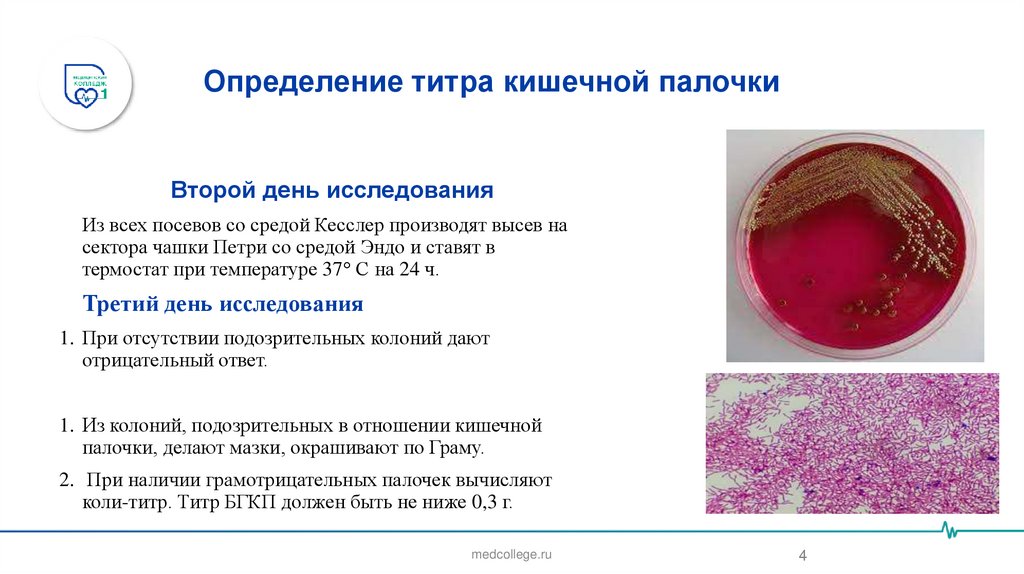
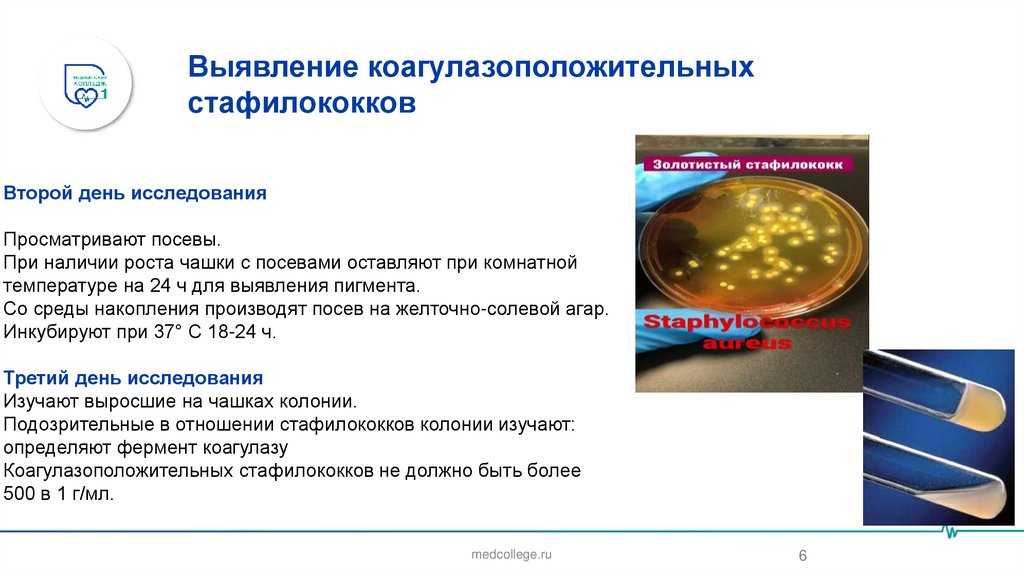

Similar presentations:
Санитарно-бактериологическое исследование крема и изделий из крема
1.
Департамент здравоохранения города МосквыГосударственное бюджетное профессиональное образовательное учреждение
Департамента здравоохранения города Москвы
«Медицинский колледж № 1»
(ГБПОУ ДЗМ «МК № 1»)
Санитарно-бактериологическое
исследование крема и изделий из крема
Аюбова Г.Ш.
Москва
2025
2.
гемагглреакции торможения непрямойгемаггСанитарно-бактериологическое
Санитарно-бактериологическое исследование
крема и изделийкрема
из крема
исследование
и изделий из
кремалютинации(РТНГА)ютинации(РТНГА)
• Санитарно-бактериологическое исследование крема проводят
соответственно
методическим
указаниям № 1351-75, утвержденным
мента
(РСК).кций
свя
Министерством здравоохранения РФ, которые предусматривают:
1. Определение титра кишечной палочки.
2. Определение плазмокоагулирующих стафилококков в 1 г
изделий.
• Отбор проб.
Пробы крема берут с поверхности и из прослойки. Пробу снимают
стерильной ложкой в количестве 50 г и помещают в стерильную
стеклянную посуду.
medcollege.ru
2
3.
Определение титра кишечной палочкиПервый день исследования
Собранный материал ставят в термостат или водяную баню при
температуре не выше 43-45° С. Для исследования используют
нижнюю часть растопленного крема.
Из исследуемого материала делают 3 десятикратных разведения:
1:10, 1:100, 1:1000.
10 мл разведения 1:10 засевают в колбу с 50 мл среды Кесслер.
Остальные разведения (1:100 и 1:1000) засевают по 1 мл в 5 мл
среды Кесслер в пробирках.
Посевы ставят в термостат при температуре 43° С на 24 ч.
medcollege.ru
3
4.
Определение титра кишечной палочкиВторой день исследования
Из всех посевов со средой Кесслер производят высев на
сектора чашки Петри со средой Эндо и ставят в
термостат при температуре 37° С на 24 ч.
Третий день исследования
1. При отсутствии подозрительных колоний дают
отрицательный ответ.
1. Из колоний, подозрительных в отношении кишечной
палочки, делают мазки, окрашивают по Граму.
2. При наличии грамотрицательных палочек вычисляют
коли-титр. Титр БГКП должен быть не ниже 0,3 г.
medcollege.ru
4
5.
Выявление коагулазоположительныхстафилококков
Первый день исследования
0,1 г растопленного крема засевают на молочно-солевой агар и
ставят в термостат при температуре 37° С на 24 ч.
Параллельно по 0,5 мл засевают в 2 пробирки с 5 мл 6,5-10%
солевого бульона (среда накопления) с последующим пересевом на
желточно-солевой агар.
medcollege.ru
5
6.
Выявление коагулазоположительныхстафилококков
Второй день исследования
Просматривают посевы.
При наличии роста чашки с посевами оставляют при комнатной
температуре на 24 ч для выявления пигмента.
Со среды накопления производят посев на желточно-солевой агар.
Инкубируют при 37° С 18-24 ч.
Третий день исследования
Изучают выросшие на чашках колонии.
Подозрительные в отношении стафилококков колонии изучают:
определяют фермент коагулазу
Коагулазоположительных стафилококков не должно быть более
500 в 1 г/мл.
medcollege.ru
6
7.
Самостоятельная работа1. Что определяют в креме и кремовых изделиях?
2. Как определяют титр плазмокоагулирующего
стафилококка?
medcollege.ru
7

biology
biology








